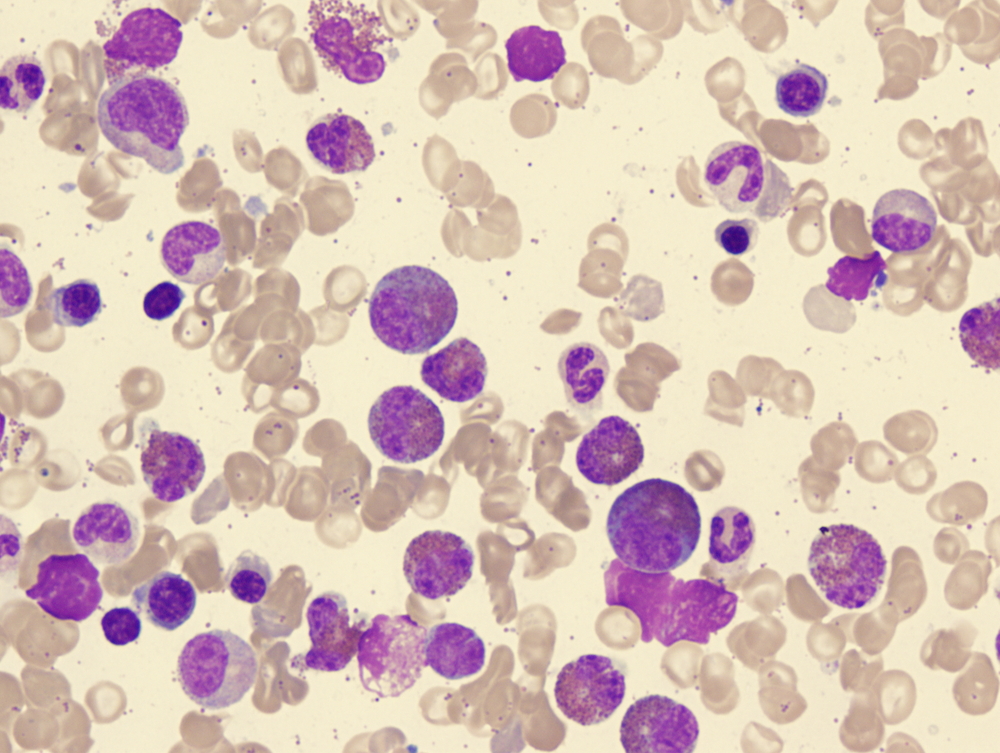

Синдром Чарга-Стросса — редкое и серьезное системное заболевание, характеризующееся некротизирующим васкулитом сосудов среднего и малого калибра, гипереозинофилией и бронхиальной астмой. Понимание симптомов и лечения этого синдрома важно для своевременной диагностики и эффективного управления заболеванием, что может улучшить качество жизни пациентов и предотвратить осложнения. В этой статье рассмотрим ключевые аспекты синдрома Чарга-Стросса, чтобы помочь читателям осознать его проявления и подходы к терапии.
Симптомы
В течение синдрома хронической усталости (СЧС) выделяют три основных этапа.
Первый этап, известный как продромальный, затрудняет точную диагностику заболевания. Он может продолжаться от одного-двух лет до десяти, а в некоторых случаях даже до тридцати лет. В этот период наблюдаются различные аллергические реакции:
- Поллиноз (сезонная аллергия на пыльцу растений с апреля по сентябрь): проявляется насморком, зудом и покраснением глаз, слезотечением, а также першением в горле.
- Аллергический ринит (круглогодичный) проявляется чиханием, выделениями из носа, зудом после контакта с аллергенами (пыль, домашние клещи, шерсть животных).
- Бронхиальная астма (приступы затрудненного дыхания, кашель, свистящие хрипы).
Иногда аллергический ринит может стать одним из первых признаков СЧС. Он может сохраняться на протяжении многих лет и часто сопровождается образованием полипов в носу и рецидивирующими синуситами (гайморитом, фронтитом, этмоидитом). Для синуситов характерны заложенность носа, головная боль (усиливающаяся при наклонах головы), а также боли в области лба и верхнечелюстной зоны.
Второй этап характеризуется повышением уровня эозинофилов в крови и тканях.
Что может вызвать беспокойство? В норме содержание эозинофилов в клиническом анализе крови составляет до 5%. Превышение этого показателя называется эозинофилией. Если уровень эозинофилов превышает 10%, необходимо пройти дополнительное обследование. На этом этапе, из-за инфильтрации тканей эозинофилами, возможно развитие эозинофильной пневмонии (кашель, одышка) или эозинофильного гастроэнтерита (жидкий стул, боли в животе).
Третий этап характеризуется проявлениями системного васкулита, что означает воспаление стенок сосудов в различных системах органов, а не только в одном конкретном органе. На этом этапе появляются общая слабость, повышение температуры тела, потеря веса, а иногда и боли в суставах и мышцах. Также могут развиваться полиорганные поражения.
Синдром Чарга-Стросса представляет собой редкое, но серьезное заболевание, которое требует внимательного подхода со стороны медицинских специалистов. Врачи отмечают, что основными симптомами являются воспаление кровеносных сосудов, что может приводить к различным осложнениям, включая проблемы с дыханием и почками. Также часто наблюдаются кожные высыпания и неврологические расстройства.
Лечение синдрома требует комплексного подхода. Врачи подчеркивают важность ранней диагностики и назначения иммуносупрессивной терапии, которая помогает контролировать воспалительные процессы. Кроме того, поддерживающая терапия, направленная на улучшение качества жизни пациентов, играет ключевую роль. Специалисты рекомендуют регулярное наблюдение и индивидуальный подход к каждому случаю, так как проявления заболевания могут значительно варьироваться.
https://youtube.com/watch?v=ldP_MEWBJlo
Какие органы поражаются чаще?
| Категория | Симптомы/Признаки | Принципы лечения |
|---|---|---|
| Общие симптомы | Лихорадка, недомогание, потеря веса, утомляемость, миалгия, артралгия | Иммуносупрессивная терапия (глюкокортикостероиды, циклофосфамид, азатиоприн, метотрексат), биологическая терапия (меполизумаб, ритуксимаб) |
| Дыхательная система | Астма (часто тяжелая, с поздним началом), ринит, синусит, полипы в носу, легочные инфильтраты, плеврит, кровохарканье | Бронходилататоры, ингаляционные глюкокортикостероиды, системные глюкокортикостероиды, иммуносупрессанты |
| Нервная система | Мононеврит мультиплекс (онемение, слабость, боль в конечностях), полинейропатия, центральные неврологические нарушения (инсульт, судороги, энцефалопатия) | Глюкокортикостероиды в высоких дозах, циклофосфамид, плазмаферез (при тяжелых формах) |
| Сердечно-сосудистая система | Кардиомиопатия, миокардит, перикардит, сердечная недостаточность, аритмии, артериальная гипертензия | Глюкокортикостероиды, иммуносупрессанты, симптоматическая терапия сердечной недостаточности и аритмий |
| Кожа | Пурпура, узелки, язвы, сетчатое ливедо, крапивница | Глюкокортикостероиды, иммуносупрессанты |
| Желудочно-кишечный тракт | Боль в животе, диарея, кровотечения, перфорация кишечника, ишемический колит | Глюкокортикостероиды, иммуносупрессанты, хирургическое вмешательство (при осложнениях) |
| Почки | Гломерулонефрит (редко, но может быть тяжелым), почечная недостаточность | Глюкокортикостероиды, циклофосфамид, плазмаферез |
| Лабораторные показатели | Эозинофилия (часто >10%), повышение СОЭ, С-реактивного белка, ANCA (антинейтрофильные цитоплазматические антитела, особенно p-ANCA/MPO-ANCA) | Мониторинг эффективности лечения по снижению эозинофилии и воспалительных маркеров |
| Прогноз | Зависит от тяжести поражения органов, особенно сердца и почек. Ранняя диагностика и агрессивное лечение улучшают прогноз. | Поддерживающая терапия, профилактика рецидивов, регулярное наблюдение |
Легкие
Если у пациента ранее были эпизоды бронхиальной астмы, в данный период приступы становятся более частыми и тяжелыми, а их купирование с помощью ингаляторов затрудняется.
Пациента могут беспокоить следующие симптомы:
- приступы удушья;
- одышка (затрудненное дыхание), возникающая как при физической активности, так и в состоянии покоя;
- кашель, сопровождающийся отхождением мокроты или без него.
Также может возникнуть клиническая картина, схожая с пневмонией (кашель, слабость, боли в грудной клетке) или плевритом (усиливающаяся одышка и появление болей в грудной клетке).
https://youtube.com/watch?v=qxqonfTW-MQ
Желудочно-кишечный тракт
Пациенты жалуются на боли в животе, которые не имеют четкой локализации, а также на диарею, возникающую 3-4 раза в день. В более серьезных случаях может наблюдаться желудочно-кишечное кровотечение: на фоне сильной слабости появляется рвота, напоминающая кофейную гущу, черный дегтеобразный стул или наличие крови в кале.
Сердце
Возможные осложнения:
- перикардит (воспаление оболочки сердца);
- коронарит (воспаление сосудов, которые питают сердечную мышцу — миокард);
- миокардит (воспаление сердечной мышцы);
- в редких случаях — инфаркт миокарда.
При этом могут возникать дискомфорт, боли за грудиной или в левой части грудной клетки, ощущение перебоев в сердечном ритме, учащенное сердцебиение, а также одышка при физической нагрузке. Со временем может развиться сердечная недостаточность.
Головной мозг
Около 25% пациентов сталкиваются с нарушениями поведения, инсультами и психическими заболеваниями.
Периферическая нервная система
У пациентов наблюдаются моно- и полиневриты, а также полинейропатии. На фоне мышечной слабости и болей в конечностях они часто отмечают онемение и чувство покалывания, как будто по коже кистей и стоп ползают мурашки.
Кожа
Изменения на коже могут проявляться на любом этапе заболевания, однако они не являются специфическими. На кожных покровах можно заметить:
- петехии (небольшие кровоизлияния, известные как «синяки» красного цвета, которые со временем могут потемнеть до коричневого);
- крапивницу (розовые или красноватые высыпания, имеющие овальную, круглую или неправильную форму, иногда сливающиеся между собой);
- эритему (красные папулы или пятна);
- сетчатое ливедо (узор на коже в виде древовидных или ветвистых линий);
- подкожные узелки.
Почки
Гломерулонефрит (воспаление клубочков почек) часто диагностируется вместе с повышением артериального давления.
Диагностика
Как видно из вышеизложенного, самостоятельно диагностировать синдром Чарга-Стросса в домашних условиях невозможно. Из-за разнообразия проявлений этого заболевания пациенты часто оказываются в различных отделениях: пульмонологии, ревматологии, неврологии и терапии. На этапе диагностики необходимо исключить множество заболеваний, сопровождающихся эозинофилией, таких как узелковый периартериит, хроническая эозинофильная пневмония, гранулематоз Вегенера, паразитарные инфекции, идиопатический гиперэозинофильный синдром и другие. Обычно, после проведения дополнительных исследований и консультаций с различными специалистами, диагноз устанавливается группой врачей (консилиумом).
Для синдрома Чарга-Стросса были разработаны и утверждены следующие диагностические критерии:
- Наличие астмы.
- Аллергические реакции в анамнезе (аллергический ринит или пищевая, контактная аллергия, за исключением лекарственной).
- Эозинофилия.
- Моно- или полинейропатия.
- Синуситы.
- Легочные инфильтраты (выявляются при рентгенографии).
- Наличие эозинофилов во внесосудистом пространстве (определяется при биопсии).
Для диагностики проводятся следующие лабораторные исследования:
- клинический анализ крови;
- общий анализ мочи;
- биохимический анализ крови;
- иммунологическое исследование крови (определение общего иммуноглобулина Е, ANCA с специфичностью к миелопероксидазе и другие — по необходимости);
- уровень С-реактивного белка, ревматоидный фактор;
- анализ мокроты на содержание эозинофилов.
При необходимости также проводятся:
- ЭКГ (электрокардиограмма);
- ЭХО КС (эхокардиоскопия = УЗИ сердца);
- рентгенография органов грудной клетки;
- УЗИ органов брюшной полости;
- рентгенография придаточных пазух носа;
- гастродуоденоскопия;
- мультиспиральная компьютерная томография (МСКТ) головы, придаточных пазух носа, грудной клетки, брюшной полости и других областей;
- допплерография артерий и вен конечностей;
- МРТ спинного мозга и пояснично-крестцового отдела позвоночника;
- электронейромиография (при вовлечении периферической нервной системы);
- пункция костного мозга.
Лечение
Лечение осуществляется в условиях стационара.
- В первую очередь назначается основная терапия с использованием глюкокортикоидов (гормонов). Сначала проводится пульс-терапия (внутривенное введение метилпреднизолона), после чего пациент переходит на прием таблеток преднизолона. Курсы пульс-терапии периодически повторяются. Полное прекращение приема глюкокортикоидов возможно не ранее чем через год после начала лечения.
- При тяжелом течении заболевания и недостаточной эффективности гормональной терапии к лечению добавляются цитостатики (циклофосфамид, азатиоприн).
- Плазмаферез применяется при быстром прогрессировании васкулита и наличии в медицинском учреждении необходимого оборудования для этой процедуры.
- Ингаляционные кортикостероиды (бекламетазон, флексотид, флутиказон), ингаляционные бронхолитики (сальбутамол, фенотерол, сальметерол) или комбинированные ингаляторы («Серетид») используются при наличии бронхиальной астмы.
- Остальные препараты являются симптоматическими и назначаются в зависимости от степени выраженности и локализации воспалительного процесса.
В заключение следует подчеркнуть, что после диагностики заболевания и получения стационарного лечения необходима поддерживающая терапия под контролем врача.
https://youtube.com/watch?v=MoiCp0oswhc
Причины и факторы риска
Синдром Чарга-Стросса (Churg-Strauss syndrome), также известный как эозинофильный гранулематоз с полиангиитом, представляет собой редкое аутоиммунное заболевание, которое характеризуется воспалением кровеносных сосудов (васкулитом) и повышенным уровнем эозинофилов в крови. Причины возникновения этого синдрома до конца не изучены, однако существует несколько факторов, которые могут способствовать его развитию.
Одним из основных факторов риска является наличие астмы или аллергических заболеваний. Исследования показывают, что большинство пациентов с синдромом Чарга-Стросса имеют историю астмы, что указывает на возможную связь между этими состояниями. Астма может служить триггером для воспалительных процессов, которые приводят к развитию синдрома.
Кроме того, существует предположение о генетической предрасположенности к данному заболеванию. У некоторых пациентов отмечается наличие семейной истории аутоиммунных заболеваний, что может указывать на наследственные факторы, способствующие развитию синдрома Чарга-Стросса.
Экологические факторы также играют важную роль. Воздействие определенных химических веществ, таких как пестициды и растворители, может увеличить риск развития синдрома. Некоторые исследования связывают синдром с воздействием на организм определенных инфекций, однако эта связь требует дальнейшего изучения.
Наконец, важно отметить, что синдром Чарга-Стросса может развиваться у людей, принимающих некоторые лекарства, особенно нестероидные противовоспалительные препараты (НПВП) и антибиотики. В редких случаях эти препараты могут вызывать аллергические реакции, которые приводят к воспалению и развитию синдрома.
Таким образом, синдром Чарга-Стросса является сложным заболеванием, причины которого могут быть многофакторными. Понимание факторов риска и причин, способствующих его развитию, может помочь в ранней диагностике и лечении данного состояния.
Прогноз и качество жизни
Прогноз при синдроме Чарга-Стросса может варьироваться в зависимости от тяжести заболевания, своевременности диагностики и начала лечения, а также от индивидуальных особенностей пациента. Важно отметить, что это редкое заболевание, и его проявления могут быть разнообразными, что затрудняет предсказание исхода.
Одним из ключевых факторов, влияющих на прогноз, является степень вовлечения органов и систем. При легкой форме синдрома, когда симптомы минимальны и не требуют интенсивного лечения, пациенты могут вести практически нормальную жизнь. Однако в случаях с более тяжелыми проявлениями, такими как значительное поражение легких или сердца, прогноз может быть менее благоприятным.
Качество жизни пациентов с синдромом Чарга-Стросса также зависит от адекватности и своевременности лечения. Современные методы терапии, включая иммуносупрессивные препараты, могут значительно улучшить состояние пациентов и снизить выраженность симптомов. Однако лечение требует постоянного мониторинга и может сопровождаться побочными эффектами, что также влияет на общее самочувствие.
Важно учитывать, что синдром Чарга-Стросса может иметь рецидивирующий характер, и пациенты должны быть готовы к возможным обострениям. Регулярные медицинские осмотры и контроль за состоянием здоровья помогут своевременно выявить изменения и скорректировать лечение.
Психологический аспект также играет значительную роль в качестве жизни пациентов. Стресс, связанный с хроническим заболеванием, может негативно сказываться на общем состоянии. Поддержка со стороны семьи, друзей и медицинских специалистов, а также участие в группах поддержки могут помочь пациентам справиться с эмоциональными трудностями.
В заключение, прогноз и качество жизни при синдроме Чарга-Стросса зависят от множества факторов, включая индивидуальные особенности пациента, степень заболевания и эффективность лечения. Своевременная диагностика и комплексный подход к терапии могут значительно улучшить исход и повысить уровень жизни пациентов.
Психологические аспекты и поддержка пациентов
Синдром Чарга-Стросса, являясь редким заболеванием, оказывает значительное влияние не только на физическое состояние пациента, но и на его психологическое благополучие. Психологические аспекты данного синдрома требуют особого внимания, поскольку они могут существенно влиять на качество жизни и процесс лечения.
Пациенты с синдромом Чарга-Стросса часто сталкиваются с множеством эмоциональных и психологических трудностей. Это может включать в себя чувство тревоги, депрессии, а также страх перед будущим и неопределенностью, связанной с состоянием здоровья. Наличие хронического заболевания, требующего постоянного медицинского наблюдения и лечения, может вызывать у пациентов ощущение изоляции и одиночества. Важно отметить, что такие эмоции являются нормальной реакцией на сложные обстоятельства, с которыми сталкиваются пациенты.
Поддержка со стороны семьи, друзей и медицинских работников играет ключевую роль в психологическом состоянии пациентов. Эмоциональная поддержка может помочь уменьшить уровень стресса и тревоги, а также повысить уверенность в себе. Важно, чтобы близкие люди были информированы о заболевании и его последствиях, что позволит им лучше понять и поддержать пациента в трудные моменты.
Психотерапия также может быть полезным инструментом в работе с пациентами, страдающими синдромом Чарга-Стросса. Индивидуальные и групповые сеансы психотерапии могут помочь пациентам справиться с эмоциональными трудностями, развить навыки копинга и улучшить общее психоэмоциональное состояние. Психотерапевты могут использовать различные подходы, включая когнитивно-поведенческую терапию, которая помогает изменить негативные мысли и поведение, связанные с заболеванием.
Кроме того, важно учитывать, что пациенты могут испытывать трудности в адаптации к новым условиям жизни, связанным с синдромом Чарга-Стросса. Это может включать в себя изменения в образе жизни, ограничение физической активности и необходимость регулярного медицинского наблюдения. Поддержка в адаптации к этим изменениям, а также обучение навыкам самоуправления и управления симптомами, может значительно улучшить качество жизни пациентов.
В заключение, психологические аспекты синдрома Чарга-Стросса требуют комплексного подхода, включающего как медицинскую, так и психологическую поддержку. Обеспечение эмоциональной поддержки, доступ к психотерапии и обучение навыкам адаптации могут существенно помочь пациентам справиться с вызовами, связанными с этим заболеванием, и улучшить их общее качество жизни.